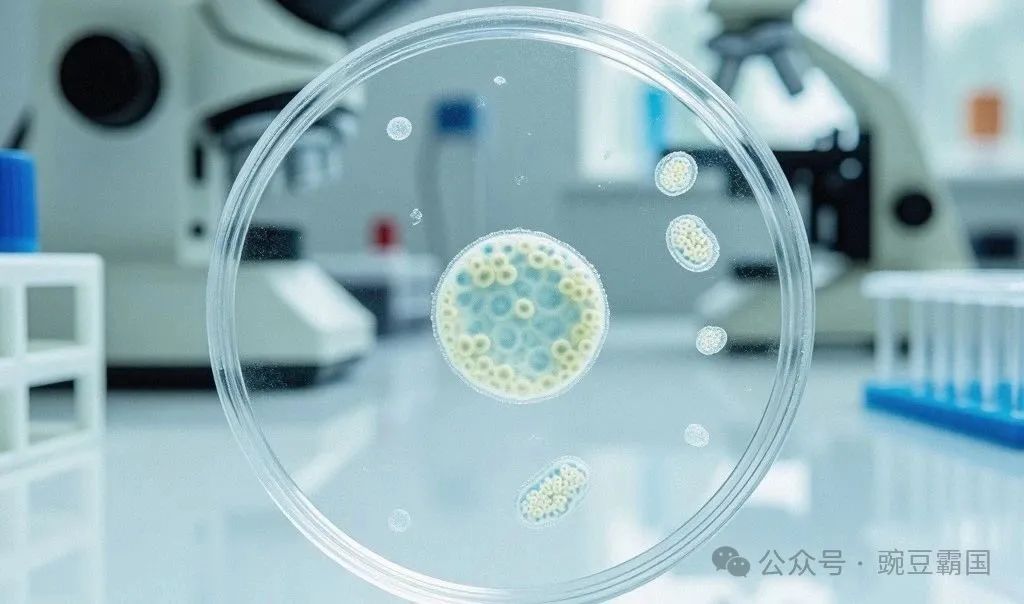

年龄差一点,结果差很多

国际权威期刊《生殖与不育》的研究分析了 11335 个经三代筛查确认的整倍体胚胎(绝对的 “优质种子”),结果让人大跌眼镜:
|
|
|
|
|---|---|---|
|
|
|
|
|
|
|
|
|
|
|
|
|
|
|
|
|
|
|
|
三大 “拦路虎” 藏在年龄背后

优质胚胎就像 “好种子”,但能不能发芽结果,还得看土壤(子宫内膜)、气候(母体环境)。大龄女性的这几大问题,可能让 “好种子” 白瞎:
1. 子宫内膜 “老化”,留不住胚胎
子宫内膜是胚胎的 “第一故乡”,但 35 岁后,内膜可能出现这些问题:
- 土壤变硬
:肌瘤、腺肌症、息肉像 “石块”,挤占胚胎着床空间; - 血流不足
:内膜血供减少,胚胎得不到足够 “养分”; - 炎症捣乱
:慢性炎症让内膜处于 “警戒状态”,会 “排斥” 胚胎。
研究显示,有宫腔粘连史的女性,优质胚胎着床率比正常人低 30%。
2. 身体 “代谢乱了”,胚胎难扎根
大龄女性更容易出现胰岛素抵抗、血糖异常,就像给胚胎的 “生长环境” 加了 “毒素”:
-
胰岛素过高会刺激卵巢分泌过多雄激素,打乱内膜 “种植窗口”; -
血糖波动大可能导致胚胎 “营养不良”,增加早期流产风险。
临床发现,有胰岛素抵抗的女性,优质胚胎移植后流产率是正常女性的 2 倍。
3. 线粒体 “没电了”,供能跟不上
线粒体是细胞的 “能量工厂”,年龄大了,线粒体功能下降,就像工厂 “电力不足”:
-
胚胎着床需要大量能量,线粒体 “罢工” 会导致着床失败; -
孕期供能不足,可能引发胎儿发育迟缓。

普通胚胎也能成,关键在内膜

有位 36 岁女士,多次移植 4AA 级优质胚胎都失败,检查发现:
-
她有子宫内膜异位症,盆腔粘连,内膜总是 “发炎”; -
还有胰岛素抵抗,血糖忽高忽低。
经过 3 个月调理:控制炎症、改善内膜血流、调节血糖,最后移植了一枚 4BB 级胚胎(质量不如 4AA),竟然成功了!
这说明,内膜和身体状态调好,普通胚胎也能逆袭;状态不好,顶级胚胎也可能 “浪费”。
移植前,做好这 4 件事

1. 给内膜 “做个体检”
-
做三维 B 超,看看有没有息肉、肌瘤、粘连; -
查内膜血流(用超声多普勒),血流好的内膜更 “肥沃”。
2. 给身体 “调代谢”
-
查血糖、胰岛素(空腹和餐后 2 小时),有问题及时调理; -
每天走 30 分钟,改善胰岛素敏感性,帮内膜 “回血”。
3. 给免疫 “降降火”
-
查抗核抗体、抗磷脂抗体,排除免疫性 “排斥”; -
避免熬夜、压力大(压力会让免疫紊乱)。
4. 移植时机 “掐准点”
-
用 B 超监测内膜厚度(8-12mm 最佳)和激素水平(雌孕激素比例合适); -
必要时做 “内膜容受性检测”,找到自己的 “最佳种植日”。

优质胚胎是好牌,但得会打

优质胚胎就像手里的 “王牌”,但能不能赢,还得看你怎么 “出牌”(身体状态)。年龄大了别只盯着胚胎质量,把内膜调理好、身体调顺了,哪怕是普通胚胎,也可能给你惊喜。
记住,试管成功 = 好胚胎 + 好土壤 + 好环境。别让 “好种子” 毁在 “差土壤” 里,提前调理,才能让每一颗胚胎都不被浪费!